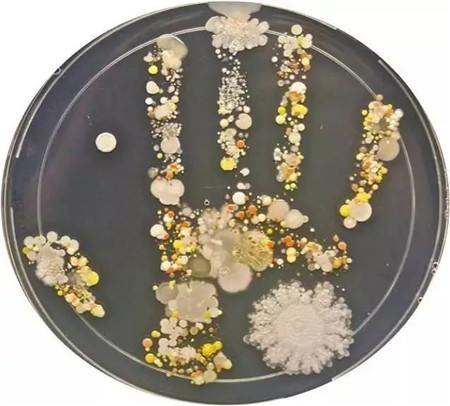

觸目驚心!手上細(xì)菌竟與臟馬桶“媲美”!
看不見摸不著的病菌就潛伏在我們的身邊,看似干凈整潔的地方,也許就是你讓你致病的病菌溫床!據(jù)美國最新研究發(fā)現(xiàn),每個(gè)人的雙手平均攜帶1000萬個(gè)細(xì)菌,甚至比抹布、電梯扶手還要臟。
太恐怖了!
我們的手竟然這么臟
美國微生物學(xué)家塔莎,在他八歲的兒子外出玩耍歸來之后,讓他在細(xì)菌培養(yǎng)皿上印的一個(gè)手印,經(jīng)48小時(shí)培育,原本肉眼無法看到的細(xì)菌繁衍成群呈現(xiàn)在了我們眼前。
看完這張照片,小編已經(jīng)無法直視自己的雙手了!
而英國有一項(xiàng)調(diào)查也顯示:11%調(diào)查者手上攜帶的細(xì)菌的數(shù)量和種類竟然可以跟廁所里面的臟馬桶“媲美”......

除了細(xì)菌,手上還可能會(huì)攜帶著各種病毒,像肝炎病毒、流感病毒、麻疹病毒、腸道病毒等等~家長們深惡痛絕的手足口病和皰疹性咽峽炎等也是可以通過“臟手”傳播的呢。
當(dāng)我們的手接觸到這些細(xì)菌之后,如果不注意清潔,就可能造成細(xì)菌隨著食物而進(jìn)入身體,并容易誘發(fā)各種疾病。
紅眼病

手足口病

肺炎

腹瀉

很多人都知道要養(yǎng)成勤洗手的習(xí)慣,可是洗手雖然能減少手部皮膚的細(xì)菌數(shù)量,卻不能防止細(xì)菌滋生。
仔細(xì)想一想我們?nèi)粘I钪斜苊獠涣伺c人、物接觸,比如我們常接觸的電梯按鈕、門把手、公交車扶手、手機(jī)……
手是細(xì)菌的傳播媒介,各種細(xì)菌和病毒都會(huì)通過手進(jìn)入人體。就拿每天都會(huì)用到的手機(jī)來說,有調(diào)查顯示,一部用了一段時(shí)間的手機(jī),每平方厘米就駐扎了12萬個(gè)細(xì)菌,按照這樣推算,整部手機(jī)的細(xì)菌可以達(dá)到上百萬個(gè)。
難道每次摸一次握手,每一次摸手機(jī)、每一次開門就洗手?
專家提醒:日常做好抗菌防護(hù),才能不受細(xì)菌侵害!
【宜護(hù)適·抗菌護(hù)盾】具有高達(dá)99.99%的抗菌能力,對大腸桿菌及化膿性球菌、白色念球菌等均有抗菌作用,只需一搖一噴,就能在膚表形成長效抗菌防護(hù)膜,24小時(shí)長效阻斷外界接觸性致病菌的侵襲。
◆ 強(qiáng)效抗菌 ◆ 長效防護(hù)
◆ 杜絕病毒傳播 ◆ 提升防御機(jī)制

使用說明:
用前搖一搖,噴一噴,
干燥即可起效。
簡單水洗或溫度變化也不影響抗菌防護(hù)效果。
(編輯:hzhb88)




















